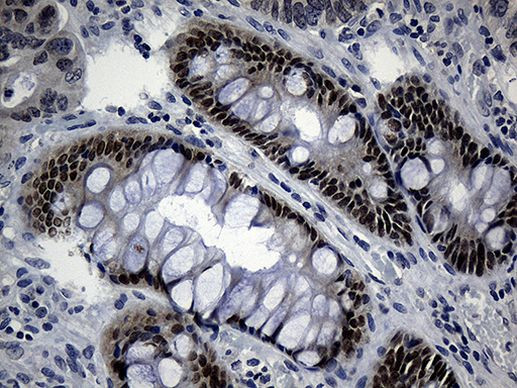
CDX1 Antibody in Immunohistochemistry (Paraffin) (IHC (P))

Search
OriGene
CDX1 Monoclonal Antibody (OTI3A1), TrueMAB™
{{$productOrderCtrl.translations['antibody.pdp.commerceCard.promotion.promotions']}}
{{$productOrderCtrl.translations['antibody.pdp.commerceCard.promotion.viewpromo']}}
{{$productOrderCtrl.translations['antibody.pdp.commerceCard.promotion.promocode']}}: {{promo.promoCode}} {{promo.promoTitle}} {{promo.promoDescription}}. {{$productOrderCtrl.translations['antibody.pdp.commerceCard.promotion.learnmore']}}
产品信息
TA810533
种属反应
宿主/亚型
分类
类型
克隆号
抗原
偶联物
形式
浓度
规格
纯化类型
保存液
内含物
保存条件
运输条件
靶标信息
CDX1, or caudal type homeobox 1, is a gene encoding a homeodomain transcription factor that plays a significant role in the development and differentiation of intestinal epithelial cells. CDX1 is expressed in the intestinal crypts, where it is integral to the Wnt/B-catenin signaling pathway, crucial for cell proliferation. Interestingly, while CDX1 expression is initially active, its expression is often silenced as colon cancer progresses in humans, suggesting a complex role in tumor biology. The CDX1 protein functions as a transcriptional regulator that influences proliferation and differentiation, expressing early during intestinal development. In mice, it is involved in the development of the posterior embryo and is associated with abnormal differentiation in metaplastic and neoplastic tissues, providing insight into intestinal-type gastric adenocarcinoma progression. CDX1 is related to other vertebrate Cdx genes such as Cdx2 and Cdx4, which are homologues of the Drosophila caudal gene and are also implicated in embryonic development.
仅用于科研。不用于诊断过程。未经明确授权不得转售。
篇参考文献 (0)
生物信息学
蛋白别名: caudal type homeo box transcription factor 1; caudal type homeobox transcription factor 1; Caudal-type homeobox protein 1; caudal-type homeobox protein CDX1; Homeobox protein CDX-1
基因别名: CDX1
UniProt ID: (Human) P47902
Entrez Gene ID: (Human) 1044